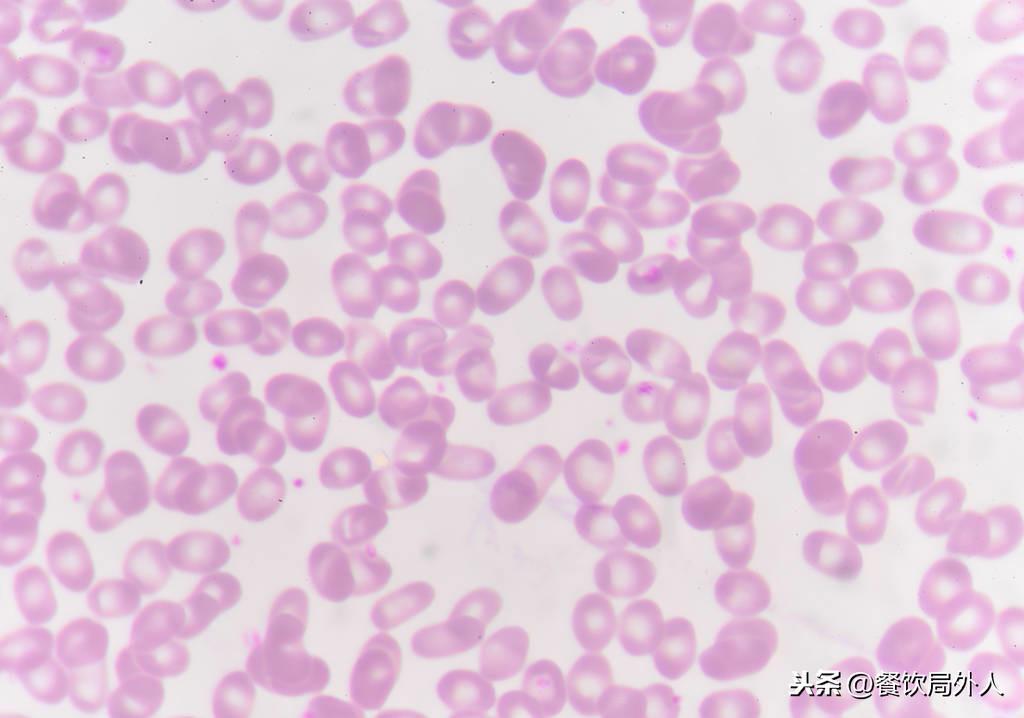

作为蒲城人,我希望蒲城并入大西安
作为蒲城人,我希望蒲城并入大西安 本文已授权“西安城记”独家发布,内容有调整修改! 最近几天,我看到很多人都在讨论“蒲城县正在规划撤县设区”的话题。从蒲城官方的报道...
盘点人类史上最致命的十大传染疾病,78%人类新发传染病源于动物
盘点人类史上最致命的十大传染疾病,大多数来自于野生动物,所以尽量少接触野生动物,已经养了野生动物的要注意卫生防护。

简介:
人类史上最大的杀手之一,疟疾。这种疾病好像一直都存在于人类身上。大约是从5000年前,疟疾从非洲西部出发逐渐传播到世界各地。一直到20世纪初全面爆发,在过去100年里,因疟疾导致了全球大约3亿人死亡。如今,在欧洲和美洲各地虽然已经全力预防,但每年仍有超过100万人死于疟疾,其中绝大多数发生在撒哈拉以南非洲地区。
疾病来源:
疾病来源于一种疟原虫,它是一种很奇怪的微生物,只由一个单细胞构成。
传播方式:
他们是完全依赖蚊子生存的寄生虫,疟疾通常是从昆虫咬伤而感染的。在昆虫的唾液腺中,上千孢子等待着昆虫唾液渗透到皮肤中。入侵后他们立即前往肝脏,悄悄地进入大细胞,藏起来不被免疫系统发现,在这里呆一个月。以隐身模式吞噬活细胞,然后变成下一种形式: 像裂体性孢子一样的小滴,他们自我繁殖产生成千上万个个体。
请输入图片描述
简介:
天花是一种烈性传染病,传染性极强,病死率高,有幸存活下来的人也会留下终生伤疤,影响颜值。在20世纪初天花的死亡率达到了顶峰,尽管爱德华詹纳在1796年发明了牛痘疫苗,但是还是有些来得太迟,据估算因天花致死的人已达5亿众。在20世纪50年代曾发起过大规模全球消除天花运动,一直到1980年,世界卫生组织宣布天花彻底消灭。
疾病来源:
病毒来源于牛羊等,也是因为牛出现了类似人类的天花病毒,才从牛痘中找到解决办法。而牛会生牛痘主要是蚊虫叮咬后病毒所致。
传播方式:
先是从动物身上传播到人,然后就是人传人,和现在的新型冠状病毒有很多相似之处。

传染病:西班牙流感
请输入图片描述
简介:
大多数人认为流行性感冒是一种常见的轻微疾病,但西班牙流感可不是普通的流感,它曾经直接导致接近1亿人的死亡。在1918-1919年的第一次世界大战期间,这种致命的流感肆掠全世界,并在18个月后神秘地消失了。在那个时期,西班牙流感被认为是人类历史上最致命的传染病。
疾病来源:
在1997年,美国的病理学研究专家陶本伯杰和其研究小组首次找到了引起西班牙流感病毒的RNA片断。研究小组发现关于该流感病毒的线索,但由于找到的RNA片断属于不同的基因,通过对比分析,该研究小组认为西班牙流感可能是一种H1N1流感。
而到了2001年,来自澳大利亚的科学家吉布斯通过研究后,认为西班牙流感是由猪流感病毒的一段编码“跳”到了人类流感病毒的RNA中。
传播方式:
空气传播。席卷整个地球的病毒。

请输入图片描述
简介:
结核病一直以来都是众所周知的可怕疾病。仅在二十世纪初就造成了约1亿人死亡,虽然随着人类医疗科技的飞速发展,肺结核的致死率稍有好转。可是,每年仍有大约150万人死于肺结核。肺结核的并发症会导致身体虚弱,机体免疫力减弱,抵抗疾病能力下降,从而导致的慢性心肺功能不全、全身衰竭、等是致死率居高不下的主要原因。
疾病来源:
肺结核是由结核分支杆菌引起的,它属于细菌不属于病毒。
传播方式:
空气传播,唾液等液体均可以传播。

请输入图片描述
简介:
黑色病也叫流行性淋巴腺鼠疫。它起源于14世纪早期的亚洲西南部,由于它直接摧毁了当时欧洲的60%人口,大约有1亿人而被欧洲人闻之色变。
疾病来源:
老鼠
传播方式:
空气传播

请输入图片描述
简介:
除非有完全治愈艾滋病的方法面世,不然艾滋病总有一天会提升到这个名单的首位。自1981年艾滋病出现以来,人类故意传播艾滋病已经造成了2500万人的死亡。目前已经有4000万人感染了这种病毒,而每天约有14,000人被感染。但不幸的是,人们显然并没有意识到艾滋病的恐怖,人们的注意力和资本都在致力于保护经济和打击恐怖分子上了。
疾病来源:
其实现在很多专家认为,艾滋病病毒最开始可能是在大猩猩身上后传给人类的,因为通过基因溯源就能够发现人类身上的艾滋病病毒和大猩猩身上的艾滋病毒是相似的。
在1981年的时候,很多男童的患者出现了一系列的症状,在美国一些相应的科学家在这些男童的群体里面提取到了一些相关的病毒,后面经过科学家命名,就称之为艾滋病病毒。
传播方式:
体液传播

请输入图片描述
简介:
霍乱是由污水中的细菌进入人体导致的,所以食物和水的卫生问题就是引发霍乱的主要原因。虽然霍乱的直接致死率较低,但如果不及时治疗,很容易让患者因其他并发症死亡。在历史上,霍乱的爆发都是有规律的,因它已经直接导致超过4000万的受害者,而在津巴布韦,每年仍有超过3000人因霍乱致死。
疾病来源:
水中细菌
传播方式:
患者的粪便,排泄物外流后,就会引发霍乱。

请输入图片描述
简介:
这是另一种关于卫生清洁的疾病,特别在战争期间和自然灾害发生时,在卫生环境相对较差的情况下,这种疾病就很容易发生。它主要由虱子传播,人口越密集越容易爆发斑疹伤寒,例如监狱,兵营等,因此斑疹伤寒对于军队来说,可谓臭名昭著。在第一次世界大战期间,东欧爆发了一场斑疹伤寒,据说当时有300万人口感染,但在第二次世界大战期间,这种疾病终得以控制。然而,到目前为止,一些发展中国家仍有零星疫情。
疾病来源:
虱子引起的斑疹伤寒。
传播方式:
人虱为传播媒介,主要是体虱,其次为头虱,阴虱一般不传播。人虱在适宜的温度下存活(29℃左右最活跃),以吸人血为生,叮咬患者后,立克次体在虱子肠壁上皮细胞内繁殖,胀破细胞后立克次体进入肠腔,当再次叮咬人或者被人人虱死亡破碎后立克次体从人虱体内逸出,从人体破损的皮肤进入人体而感染人类。

请输入图片描述
简介:
麻疹是儿童最常见的急性呼吸道传染病之一,具有很强的传染性,可以经由空气传播。最近在美国明苏尼达州,爆发了严重的麻疹疫情,已经有40多人感染。在英国,麻疹发病率近十年来增加了20倍。
疾病来源:
麻疹病毒属副黏液病毒
传播方式:
麻疹是最常见的急性呼吸道传染病之一,其传染性很强,在人口密集且未普种麻疹疫苗的地区极易发生和流行,一般2-3年会出现一次大流行。

请输入图片描述
简介:
如今已经很少会有人因猩红热而致死了,但猩红热还是历史上最严重的儿童杀手之一。在19世纪60年代,因猩红热病致死的人数高达972万人。在整个第十九世纪,猩红热病曾席卷整个欧洲大陆,摧毁了当时欧洲25%的人口。
疾病来源:
A组链球菌
传播方式:
猩红热病毒是A组链球菌感染所致。A组链球菌也称化脓性链球菌,可侵及人体任何部位,以侵及上呼吸道最常见。细菌本身菌体成分及其产生的毒素和蛋白酶,均参与了致病过程,引起了一系列化脓性、中毒性和变态反应性病变。链球菌多由呼吸道侵入人体,首先引起咽颊炎和扁桃体炎,在其产生的蛋白酶的作用下,使炎症扩散并引起组织坏死。同时由于细菌产生的致热外毒素(红疹毒素)的作用,可引起全身毒血症表现。
综合以上历史上害人最多的病毒,大部分来自于野生动物,老鼠、虱子、猩猩、蚊虫...;所以大家喜欢养宠物,特别是野生宠物的要注意卫生防护。
作为蒲城人,我希望蒲城并入大西安 本文已授权“西安城记”独家发布,内容有调整修改! 最近几天,我看到很多人都在讨论“蒲城县正在规划撤县设区”的话题。从蒲城官方的报道...
读《通往奴役之路》-坚持和完善中国特色社会主义制度 读《通往奴役之路》——博采众长兼收并蓄,坚持和完善中国特色社会主义制度 一、引论 《The Road to Serfdom》(《通往奴役之路...
零陵古城巡礼-6-柳子庙 柳子庙 作者:邓少年 一、地理位置 :湖南省永州市零陵区朝阳镇柳子街居委会312号 二、简介 :柳子庙,位于永州市零陵区河西柳子街,为纪念唐代著名思想家...
熊汉俊牺牲真相:因隧道塌方去世,并非浇筑在桥墩之中 许多年来,网络上一直流传着一个悲壮的故事:60年代修建成昆铁路线时, 一位叫熊汉俊的战士不幸掉入龙骨甸大桥七号桥墩,...
出生于江苏昆山的科学院院士、上海中山医院院长肝癌外科专家樊嘉 在阅读此文之前,麻烦您点一下“关注”,既方便您进行讨论和分享,又能给您带来最新更新文章,感谢您的支持!...
郑州市新郑市龙湖镇,一个崛起的小城镇,一个高校林立的小镇 简介 龙湖镇隶属河南省新郑市,位于新郑市北部,东邻孟庄镇、西接新密市、南依郭店镇、北靠郑州管城区,距离郑州...
《西游记》里的八大菩萨 《西游记》作为古典文学四大名著之一,吴承恩的《西游记》叙述的是唐僧师徒西天取经的故事,塑造了神话英雄孙悟空的形象,虽写神魔而颇具人情,想象丰...
揭秘卫国公李靖,及其后代子孙,在大唐历史上留下的痕迹 大唐一代战神李靖,当时臣子之中只有李绩和他能相提并论,前半生平淡无奇,在大唐可以说开了挂一样,平岭南,灭东突厥...
痛失爱女,她的现况如何? 吉雪萍:从艺术到主持,再到教育吉雪萍是一位多才多艺的女性,她的故事充满了勇气和毅力。她最初选择了艺术之路,并在上海戏剧学院接受了专业的表演...
杭州美人王映霞: 嫁给郁达夫后出轨戴笠,改嫁普通人,2000年去世 她是民国杭州第一美人,高调嫁给郁达夫后,又选择出轨戴笠。 后又改嫁给一个普通人,活到了2000年去世。她是谁?...
大明朝的二十位书法大师,厉害 我们选取20位惊世墨客人物, 并呈献其书画墨宝与朋友们共赏之。 - 朱元璋 - 明王朝的开国皇帝 朱元璋《大军帖》 - 高启 - 助朱棣夺取皇位 高启是明初...
回忆2019年台湾第五十六届金马奖 第56届台湾电影金马奖是中国台湾电影事业发展基金会的台北金马影展执行委员会主办的电影奖项。 该届金马奖《阳光普照》获得最佳剧情长片,钟孟...
这种老祖宗玩的葫芦,很少人玩了!齐白石曾对它如痴如醉 之前铁盘妹分享过 葫芦的盘玩和挑选干货 当时有玩友留言 希望找葫芦大神 @石山杨二 来讲一讲手捻葫芦 于是,铁盘妹发挥...
觉得自己很坚强?这十部致郁动漫让你在深夜痛哭 虽然致郁系动漫每次完结时几乎都是骂声一片,但不得不承认,相比其它欢乐的Happy ending动漫而言,往往致郁动漫会让我们记得更久,...
阿根廷第一夫人:比伊万卡和布丽吉特有气质,三婚36岁带娃嫁总统 2018年12月,44岁的阿根廷第一夫人朱莉安娜·阿瓦达,穿着一身洁白的蕾丝花朵连衣裙,出席了G20峰会。 会场上作为...
为什么说1991年海湾战争打蒙了全世界,却唯独打醒了中国? 在阅读此文之前,麻烦您点击一下“关注”,既方便您进行讨论和分享,又能给您带来不一样的参与感,感谢您的支持! 九...
他是朱德总司令的朋友,在入藏劝和的路上被英国特工福特毒害 文/鹿城清扬 01 在红军和藏民之间,他搭建桥梁 1902年,四川省甘孜藏族自治县一户普通平民家里,诞生了一个男婴。这...
深圳民办高中最强榜单出炉,这些学校不输公办 最近,有家长咨询小轻想要了解一些民办高中,小轻为大家汇总了综合实力比较强的10所民办高中,文章顺序不作为学校排名顺序,孰强...
100款川味凉菜,做法精简,味道一流,大家可以收藏起来了 100款川味凉菜,做法精简,味道一流,大家可以收藏起来了。 热拌鲈鱼 1.鲈鱼宰杀治净,在鱼背肉厚处打一字刀,加少许盐...
「四川要闻」四川要闻第225—229期(2022.12.26—2023.2.5) 四川要闻 2023年第1期(总第225期) 2022年12月26日—2023年1月1日 12 月 26 日省委经济工作会议在成都举行。会议主要任务是,学习贯...
有史以来 100 部优秀美国恐怖电影 Georges Melies 1896 年的电影“Le Manoir du Diable”被认为是有史以来第一部恐怖电影,虽然在法国拍摄,但它在美国以“鬼城”的形式上映,为恐怖类型奠定...
东北方言土话大全!合集版(收藏) 东北方言土语形成 东北位于山海关以北,包括辽宁省、吉林省、黑龙江省、内蒙古东部地区。 东北的汉族人口,大部分是从中原各省迁来的,尤以...
福州大利嘉电脑城再现“蹭网器” “蹭网器”又称“无线网络破解器”,指在有无线路由器覆盖的区域中,使用特殊设备破解指定无线网络的接入限制,从而达到免费上网的作用。自...
《甄嬛传》眉庄的真实身份,竟是甄嬛的替身傀儡 我是冷傲剑,一个用情观剧的小哥。 甄嬛是上天的恩赐,一颗玲珑七窍心,对万事万物的领悟非常人能及 选秀时,一朵秋海棠,能让...